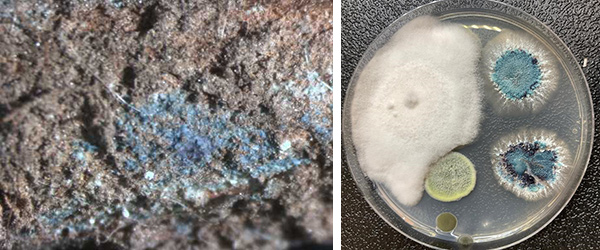
sintomo sindrome della morte improvvisa della soia

Sindrome della Morte Improvvisa della Soia
PUNTI CHIAVE
- La Sindrome della Morte Improvvisa della soia, dall’inglese Sudden death syndrome (o SDS) è diffusa nella maggior parte degli stati americani produttori di soia. In alcuni la SDS è attualmente considerata la seconda causa di perdite economiche nella soia, dopo il nematode cisticolo della soia.
- La Sindrome della Morte Improvvisa della soia è presente anche in Italia, anche se con una incidenza minore rispetto agli Stati Uniti, anche in base all’andamento stagionale.
- La Sindrome della Morte Improvvisa della soia è provocata dal fungo patogeno Fusarium virguliforme, precedentemente noto come F. solani f. sp. glycines.
- Semine anticipate e condizioni fresche e umide a inizio stagione favoriscono spesso una maggiore incidenza della SDS. La malattia tende a essere più grave quando il nematode cisticolo è già presente nel campo.
- La SDS si manifesta frequentemente in zone del campo avvallate, scarsamente drenate o compattate. L’infezione avviene all’inizio della stagione, ma i sintomi sulle foglie compaiono generalmente a metà estate.
- Con la progressiva perdita di superficie fogliare e il deterioramento dell’apparato radicale dovuto alla SDS, la resa viene ad essere compromessa: l’aborto di fiori e baccelli è frequente, con conseguente riduzione del numero di semi, che risultano spesso più piccoli. I baccelli formatisi più tardi possono non riempirsi o non maturare correttamente.
- La gravità della SDS varia notevolmente da zona a zona e da campo a campo. È quindi fondamentale che gli agricoltori valutino l’estensione dell’infezione in ciascuna delle loro parcelle per gestirla in modo efficace.
- Le pratiche di gestione includono la scelta di varietà tolleranti, il trattamento dei semi, la semina posticipata dei campi più problematici, il controllo del nematode cisticolo, il miglioramento del drenaggio degli appezzamenti, la riduzione della compattazione e la limitazione di altri fattori di stress per la coltura.
Una malattia di rilievo per la soia
La Sindrome della Morte Improvvisa è una delle principali malattie che limitano la resa della soia in Nord America. Scoperta per la prima volta in Arkansas all’inizio degli anni ’70, si è diffusa dalla valle del Mississippi a gran parte degli stati coltivatori di soia negli Stati Uniti e in Ontario, Canada. La SDS può causare perdite di resa molto significative, superando il 50% nei casi più gravi (Malvick, 2018). Negli stati del Midwest, è oggi seconda solo al nematode della cisti della soia (Heterodera glycines) in termini di impatto economico (Bandara et al., 2020). Questi dati sono coerenti con le osservazioni effettuate in Italia, pur non essendo ancora diffusa come negli Stati Uniti.
 |
| Figura 1: classici sintomi fogliari di una infezione da SDS. |
Origine e diffusione
I sintomi della malattia che oggi conosciamo come SDS sono stati documentati per la prima volta in Arkansas nel 1971. Rimase senza un nome ufficiale per oltre un decennio (Roy et al., 1997). Solo nel 1983, quando si comprese il suo impatto negativo sulla resa, fu denominata “Sindrome della Morte Improvvisa” (Hirrel, 1983). Il nome riflette due aspetti chiave: la velocità con cui si manifestano i sintomi fogliari che portano rapidamente alla morte della pianta, e l’iniziale incertezza sull’agente patogeno. Il termine “sindrome” indicava infatti un insieme di sintomi ancora senza causa certa.
Passarono altri sei anni prima che si identificasse Fusarium virguliforme come patogeno responsabile della malattia. Durante questo lasso di tempo, la SDS si era già diffusa ad altri stati. Nel 1984 fu confermata in Mississippi, Missouri, Kentucky e Tennessee, raggiungendo Illinois e Indiana nel 1985 (Roy et al., 1997). Oggi è presente in almeno 29 stati americani, coprendo gran parte dell’area coltivata a soia.
Un patogeno casuale della soia
In Nord America, la SDS è causata dal fungo Fusarium virguliforme, precedentemente noto come F. solani f. sp. glycines. Il genere Fusarium comprende oltre 1.500 specie, molte delle quali sono patogeni importanti per le piante. F. virguliforme appartiene al complesso di specie Fusarium solani (FSSC), che include più di 60 specie patogene e saprofite (Coleman, 2015).
Si ritiene che F. virguliforme sia un patogeno invasivo in Nord America, ma originario del Sud America. In quella regione, infatti, si conoscono altre tre specie di Fusarium che causano la SDS: F. tucumaniae, F. brasiliense e F. crassistipitatum (Spampinato, 2021). Studi genomici indicano che questi patogeni hanno preceduto l’introduzione della soia nel continente americano, passando probabilmente in modo casuale da altri ospiti vegetali alla soia, importata dall’Asia nel XVIII secolo (O’Donnell et al., 2010).
Ciclo di vita e sintomi della Sindrome della Morte Improvvisa della soia
Ciclo di vita
Fusarium virguliforme sopravvive principalmente sotto forma di clamidospore (Fig.2) nei residui radicali e liberamente nel suolo (Roy et al., 1997). Le clamidospore sono spore fungine asessuate a pareti spesse, che fungono da strutture di sopravvivenza per molti funghi e possono rimanere vitali nel terreno per diversi anni. Queste spore sono estremamente resistenti: sopravvivono al congelamento e sono poco sensibili alla disidratazione. Con l’aumento delle temperature primaverili, le clamidospore germinano e infettano le radici di piante di soia vicine.
 |
| Figura 2: spore di Fusarium virguliforme |
Infezione delle piante di soia
L’infezione avviene all’inizio della stagione vegetativa, spesso già dalla germinazione fino a poco dopo l’emergenza della coltura. Il fungo colonizza i tessuti corticali delle radici ed è stato individuato sia dalle radici principali che da quelle laterali, ma non si propaga oltre la corona della pianta (Roy et al., 1997). Più avanti nella stagione, F. virguliforme può penetrare nei tessuti xilematici delle radici: a questo punto, una tossina prodotta dal patogeno viene traslocata verso l’alto nella pianta, causando i caratteristici sintomi fogliari della SDS. Durante l’estate, il fungo produce spore (macroconidi) sulla superficie delle radici infette, che si trasformano in clamidospore e si distaccano con i tessuti corticali marcescenti. Nel corso di una singola stagione colturale, la diffusione di queste spore è limitata a brevi distanze dalle piante infette; tuttavia, il ruscellamento e la movimentazione del suolo possono favorire la dispersione del patogeno su distanze maggiori, sia all’interno dello stesso campo che in nuovi appezzamenti.
Fitotossina
La tossina responsabile dei sintomi fogliari della SDS è stata isolata e identificata nel 2011 (Brar et al., 2011). Il fatto che F. virguliforme non fosse mai stato osservato in foglie con sintomi della malattia e il fatto che notoriamente molte specie di Fusarium producono tossine, hanno portato gli scienziati a ipotizzare che una o più tossine potessero esserne la causa. È stata così identificata una piccola proteina, denominata FvTox1, che è la responsabile dei sintomi fogliari. È stato osservato che i danni fogliari si manifestano solo in presenza di luce, suggerendo che FvTox1 agisca interrompendo la fotosintesi, con conseguente formazione di radicali liberi che determinano clorosi e necrosi dei tessuti (Brar et al., 2011).
In più, il fatto che F. virguliforme completi l’intero ciclo vitale nelle radici della pianta solleva interrogativi sul vantaggio evolutivo derivante dal danneggiamento dei tessuti fogliari. Poiché la produzione della tossina comporta un costo metabolico per il patogeno, si presume che essa rappresenti una strategia per indebolire la pianta, riducendone la capacità fotosintetica, abbassando le difese fisiologiche contro l’infezione e facilitando così l’insediamento e la proliferazione del fungo (Brar et al., 2011).
Sintomi delle radici e del fusto
La SDS si manifesta inizialmente come patologia radicale, danneggiando e compromettendo lo sviluppo sia delle radici stesse che i noduli radicali, con conseguente riduzione dell’assorbimento di acqua e nutrienti da parte della pianta. Nelle piante gravemente infette, si può osservare una colorazione blu sulla superficie esterna delle radici principali, dovuta all’elevata concentrazione di spore (Figura 3).
|
| Figura 3: immagine al microscopio di masse di spore di colore blu sulla radice di una pianta affetta da SDS (a sinistra) e colonie di F. virguliforme su un mezzo di coltura artificiale (a destra) |
Tuttavia, queste colonie fungine potrebbero non essere visibili se il suolo risulta troppo secco o troppo umido. All’analisi delle radici, la corteccia risulta grigio-marrone e opaca, mentre il cilindro centrale (midollo) si mantiene bianco (Figura 4). La decolorazione può estendersi anche a più nodi del fusto, ma il midollo resta visivamente sano.
 |
| Figura 4: sezione di fusti di soia che mostrano decolorazioni corticali in una pianta infetta da SDS, a confronto con una pianta sana. |
Sintomi fogliari
Sebbene l’infezione da SDS avvenga subito dopo la germinazione e l’emergenza, i sintomi a carico delle foglie compaiono solo durante le fasi riproduttive, tipicamente da metà estate in poi. La comparsa dei sintomi è frequentemente associata a condizioni meteorologiche caratterizzate da temperature fresche e piogge consistenti durante la fioritura o la formazione dei baccelli. I primi sintomi fogliari si osservano solitamente 10–14 giorni dopo forti precipitazioni che saturano il suolo. L’umidità elevata favorisce la produzione e la traslocazione della tossina responsabile della manifestazione fogliare della malattia. I sintomi fogliari della SDS iniziano come macchie gialle, solitamente sulle foglie superiori, disposte in un pattern a mosaico. Le macchie gialle si uniscono formando macchie clorotiche tra le venature fogliari (Figura 5).
 |
| Figura 5:sintomi di campo della Sindrome della Morte Improvvisa della soia. Le aree gialle e brune in contrasto con la nervatura centrale e le venature laterali che restano verdi. Il rapido disseccamento delle aree necrotiche può causare l’arricciamento delle foglie colpite. |
Man mano che queste aree clorotiche cominciano a morire, i sintomi fogliari diventano più evidenti, con aree gialle e marroni in contrasto con la nervatura centrale verde e le venature laterali verdi. L’asciugamento rapido delle aree necrotiche può causare l’accartocciamento delle foglie colpite. Le foglie cadono prematuramente dalla pianta, ma i piccioli rimangono saldamente attaccati al fusto.
Sintomi su tutta la pianta
Con la perdita di superficie fogliare e il deterioramento delle radici, il raccolto viene compromesso. L’aborto dei fiori e dei baccelli è comune, con conseguente riduzione della produzione di semi, che tendono a essere più piccoli.
I baccelli che si sviluppano più tardi nella stagione potrebbero non riempirsi o i semi potrebbero non maturare completamente.
Poiché le piante e i baccelli si seccano più rapidamente, le perdite durante la raccolta potrebbero aumentare nelle piante infette da SDS. L’entità del calo produttivo dipende fortemente dalla fase di crescita della pianta di soia al momento dell’infezione e dalla rapidità con cui si manifestano i sintomi. In alcuni casi, può verificarsi la morte prematura dell’intera pianta senza i tipici sintomi di defogliazione, con le piante che ingialliscono e muoiono gradualmente.
Condizioni predisponenti la sindrome da morte improvvisa della soia
Come accade per altre patologie radicali del suolo, la SDS tende a manifestarsi inizialmente in zone localizzate del campo, come aree con avvallamenti, scarsamente drenate o soggette a compattazione. Tuttavia, in alcuni casi, gravi infezioni possono verificarsi anche in suoli altamente produttivi con elevata capacità di ritenzione idrica.
Poiché la gravità della malattia è fortemente influenzata da fattori ambientali, dal momento dell’infezione e da ulteriori stress sulla coltura, ci possono essere variazioni da un anno all’altro e all’interno delle diverse zone del campo.
L’incidenza della SDS tende ad aumentare quando la soia viene esposta a condizioni di suolo freddo e umido all’inizio della stagione vegetativa. Per questo motivo, la semina anticipata può predisporre maggiormente la coltura allo sviluppo della malattia.
I sintomi della SDS risultano generalmente più gravi quando nel campo è presente anche il nematode cisticolo della soia, che non solo intensifica lo stress per la pianta, ma crea anche ferite attraverso cui il patogeno della SDS può penetrare nelle radici.
 |
| Figura 6: sintomi di sindrome da morte improvvisa su soia trifogliata |
Distinguere la sindrome da morte improvvisa della soia da altre malattie
I sintomi fogliari della SDS possono somigliare a quelli di altre patologie della soia, come la marcescenza bruna del fusto (Cadophora gregata), il cancro del fusto (Diaporthe spp.), la marcescenza da carbone (Macrophomina phaseolina) e la marcescenza rossa della corona (Calonectria ilicicola). Esistono però alcune caratteristiche distintive che permettono di differenziare facilmente queste malattie.
Per distinguere la SDS da altre infezioni, occorre innanzitutto esaminare l’esterno del fusto. Se sono presenti lesioni affossate, di colore marrone-nero, si è probabilmente in presenza di un cancro del fusto.
Nel caso della marcescenza rossa della corona, la caratteristica più evidente è la presenza di periteci, piccoli corpi fruttiferi rossi, sulla corona e sulle radici appena sotto la superficie del suolo, conferendo una colorazione rossastra alla zona interessata.
Il carbone, invece, si può identificare raschiando i tessuti esterni del fusto: se appaiono microsclerozi neri e polverosi, la diagnosi è confermata. Se nessuno di questi sintomi è evidente, si consiglia di dividere longitudinalmente i primi 20 cm del fusto. Se si tratta di SDS, il midollo sarà bianco, mentre la corteccia circostante apparirà di colore grigio-marrone. Al contrario, nella marcescenza bruna del fusto, il midollo sarà marrone scuro e la corteccia resterà verde.
 | Sindrome della Morte Improvvisa: il tessuto corticale infetto appare grigio-marrone, mentre il midollo rimane bianco. |
 | Marcescenza bruna del fusto: il tessuto del midollo nel fusto inferiore è marrone scuro, mentre il tessuto corticale rimane verde. |
 | Carbone: decolorazione grigio chiaro sui tessuti superficiali delle radici e del fusto inferiore. Raschiando i tessuti esterni si riveleranno microsclerozi neri e polverosi. |
 | Marcescenza rossa della corona: i periteci sulla corona e sulle radici appena sotto la linea del suolo, (simili a piccole sfere rosse), conferiscono alla corona una colorazione rossastra. |
 | Cancro del fusto: grandi lesioni infossate marrone-nero sull'esterno del fusto. |
Gestione della SDS
La gravità della SDS varia notevolmente da un’area all’altra e tra campi differenti. Per questo motivo, è fondamentale che gli agricoltori identifichino con precisione il livello di infezione da SDS presente in ciascuno dei loro campi. Questo implica un monitoraggio costante durante la stagione in cui i sintomi sono visibili, anche utilizzando strumenti GPS per mappare le zone soggette alla malattia. Tali mappe possono poi essere sovrapposte a quelle di resa per identificare l’impatto produttivo della SDS.
Una volta che i sintomi fogliari si sono manifestati, non esistono misure gestionali in grado di salvaguardare la resa. I fungicidi fogliari risultano inefficaci poiché l’infezione ha luogo nelle radici.
Di conseguenza, le strategie di gestione si concentrano sul contenimento della malattia nelle stagioni successive. L’adozione integrata di diverse pratiche agronomiche può ridurre significativamente i danni causati dalla SDS.
Varietà di soia tolleranti
La prima strategia difensiva contro la SDS consiste nella scelta di varietà geneticamente tolleranti. Le varietà possono differire significativamente nella loro suscettibilità all’infezione: la tolleranza si manifesta principalmente in forma di una minore gravità dei sintomi. Per questo motivo, la selezione varietale rappresenta un elemento chiave per ridurre i danni alla pianta e le perdite di resa.
Per supportare gli agricoltori nella selezione, i ricercatori di Corteva Agriscience testano le nuove varietà in località caratterizzate da una conclamata presenza storica di SDS. Tali località sono irrigate e/o seminate precocemente per stimolare lo sviluppo della malattia.
Le varietà Pioneer® vengono valutate su una scala da 1 a 9 in base alla loro tolleranza alla SDS, dove 9 rappresenta la massima tolleranza.
Il processo di miglioramento genetico continua a rafforzare la resistenza varietale: ad esempio, le varietà della serie Pioneer Z, attualmente commercializzata solo negli Stati Uniti e introdotte nel 2024, hanno ottenuto un punteggio medio di 0,5 punti più elevato rispetto alla serie precedente A.
Anche la resistenza al nematode cisticolo della soia è un fattore cruciale: il gene rhg1b, derivato dalla fonte PI88788, ha mostrato una ridotta efficacia in molti campi, facendo riemergere l’SCN come una minaccia da gestire.
Alcune varietà d’élite stanno introducendo geni alternativi, soprattutto dalla fonte Peking (PI548402).
Corteva continuerà a sviluppare varietà ad alto potenziale produttivo con resistenza multipla, includendo anche nuove fonti di resistenza all’SCN nei prossimi anni.
Gestione del nematode cisticolo della soia
Il nematode cisticolo della soia è una problematica diffusa nei campi in cui è presente anche la SDS. Esso intensifica lo stress e crea aperture nelle radici per l’ingresso del patogeno. È stato inoltre scoperto che F. virguliforme può essere trasportato all’interno dei corpi del nematode cisticolo della soia, rendendo ancora più importante la sua gestione.
Sebbene l’SCN non possa essere completamente eradicato, è possibile contenerne la diffusione mediante:
- utilizzo di varietà resistenti,
- trattamenti per i semi efficaci contro il Nematode Cisticolo della Soia, (attualmente disponibili solo nel mercato Americano)
- rotazione delle colture, alternanza delle fonti genetiche di resistenza.
Miglioramento del drenaggio del campo e riduzione della compattazione
Questi due aspetti sono strettamente correlati: le aree umide sono più soggette a compattazione e, a loro volta, i suoli compattati trattengono più acqua. Tali condizioni favoriscono lo sviluppo della SDS (Figura 7).
 |
| Figura 7: visuale aerea di un campo di soia con infezioni da SDS: i sintomi sono prevalenti in aree con scarso drenaggio |
Le radici che già faticano a svilupparsi in suoli saturi e compattati sono ulteriormente danneggiate dalla malattia. In caso di stress, questi campi mostrano gravi cali di resa dovuti a un sistema radicale compromesso e agli effetti devastanti della tossina della SDS. È dunque prioritario migliorare il drenaggio e intervenire sulle zone compattate per ridurre il rischio.
Lavorazioni del terreno
Gli effetti delle lavorazioni del suolo sulla SDS sono stati variabili (Westphal et al., 2018): alcuni studi non rilevano alcun impatto (Kandel et al., 2019), mentre altri evidenziano una riduzione della gravità della malattia. In particolare, la lavorazione può favorire l’asciugatura e il riscaldamento del suolo in primavera.
Un esperimento dell’Università del Missouri ha evidenziato che terreni gestiti senza lavorazione presentavano percentuali di infezione fogliare molto più elevate rispetto alla discatura o alla minima lavorazione, sia a maggio che a giugno. L’accumulo di residui colturali tende a raffreddare e mantenere umido il letto di semina. Nei campi con alta pressione di SDS, è consigliabile rivalutare il sistema di lavorazione adottato.
Riduzione di altri stress
Altri tipi di stress possono aumentare la vulnerabilità della soia alla SDS. Tra questi:
- stress da erbicidi,
- carenze nutrizionali,
- pH elevato,
- pressione di parassiti.
Mantenere un livello ottimale di fertilità, ridurre la compattazione e controllare infestanti, malattie e insetti migliora la salute generale della pianta e ne rafforza la resistenza alla SDS.

